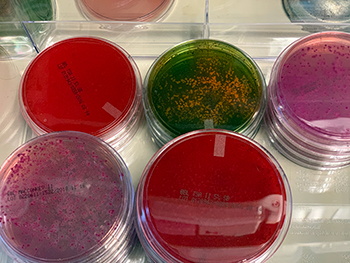

Research Areas
Research Focus
The Pimentel Laboratory focuses on the association between acute gastroenteritis and disruption of gut flora, impairment of gastrointestinal (GI) tract motility and small intestinal bacterial overgrowth (SIBO) in the pathophysiology of irritable bowel syndrome (IBS). The research includes basic science and physiology, as well as clinical and translational research. Since autoimmunity and vinculin modulation may be the root events in IBS that lead from food poisoning to SIBO, the Pimentel Lab aims to manipulate this in two ways to attain a “cure” for IBS through 1) reducing the circulating autoantibodies to CdtB, which attack vinculin, and 2) activating or enhancing vinculin activity. The Pimentel group is also pursuing therapies that target Methanobrevibacter smithii, which they hypothesize causes C-IBS. Since an antibiotic approach produces only a short-lived response, they are developing drugs that have known inhibitory effects on methane synthesis by these organisms in a “drugs for bugs” approach.
Research Highlights

| Gel electrophoresis of PCR amplification on total versus methane-producing gut bacteria. |
The Pimentel Laboratory has many ongoing basic science, translational and clinical research projects with the overarching aim of increasing our understanding of the gut microbiome and its role in human health and disease. One of the most ambitious of these is a large-scale effort to understand the small bowel microbiome for the first time. Since the small intestine is the absorbing surface, elements that bacteria produce here are more likely to be absorbed and impact health. The Pimentel Lab is convinced that these studies will lead to the development of a growing series of discoveries and potential microbiome based treatments.
Translational Research
| Cultured intestinal flora in an agar plate. |
In the laboratory, the Pimentel team has a number of research projects related to:
- Inflammation after acute gastroenteritis
- Mechanism of development of disease
- Role of host-immune responses in IBS
- Shifts in gut flora microbial species associated with disease
- Correlations between gut methane, gut transit, gut flora, constipation/diarrhea, metabolic symptoms and obesity
These studies are designed to provide answers that will lead to deeper investigations.
Clinical Studies
Colonic Inertia Pilot Study
The purpose of this pilot study is to identify the causes of a condition called colonic inertia, which involves severe constipation. Researchers aim to determine whether colonic inertia can be caused by changes in the types of microbes that are present in the colon, or possibly by a toxin produced by particular microbes.
The purpose of this study is to understand the causes of irritable bowel syndrome (IBS) by looking at both genetic and immunologic mechanisms. Examination of DNA will enable researchers to understand which gene(s) contributes to the development of IBS
Contact the Pimentel Lab
8700 Beverly Blvd.
Davis Building, Room 5009
Los Angeles, CA 90048
Twitter: @mastprogram and @MarkPimentelMD
Facebook: MarkPimentelMD